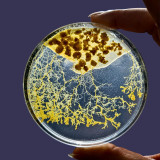
71xklpf1tbl-ac-sl1080-3541

Kit Mister Blob
15 €
- Le kit d'élevage contient tout le nécessaire pour démarrer votre élevage : 2 blobs endormis + une boite de Petri (90mm) + une pipette + une pince + 5g d'agar agar + flocons d'avoine + les instructions
- Un format minimaliste pour un petit prix ! Mais tout y est ! Bien qu'une seule boite soit fournit, vous pouvez héberger votre blob dans n'importe quel autre contenant !
- Vous n'êtes pas seuls dans l'aventure ! Une notice vous accompagne pour chaque étape : du réveil, au soin, jusqu'à rendormir votre blob... On vous dit tout, et on répond à vos questions !
- Le blob peut être réveillé quand vous le souhaitez... Dans une semaine, un mois, un an, c'est vous qui décidez ! On vous garantit son réveil dans tous les cas !
- Une expérience scientifique qui amusera petits et grands ! C'est une vrai expérience familiale ! Un cadeau fille/garçon dès 7 ans.
- Les enfants peuvent observer de près le comportement fascinant du blob dans leur propre maison. Cela encourage les enfants à s'intéresser à la science et à l'environnement de façon amusante.